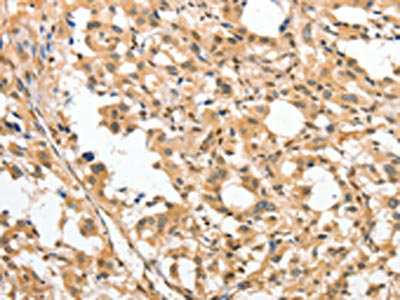

APTX Antibody
-
中文名稱:APTX兔多克隆抗體
-
貨號:CSB-PA552720
-
規(guī)格:¥1100
-
圖片:
-
The image on the left is immunohistochemistry of paraffin-embedded Human thyroid cancer tissue using CSB-PA552720(APTX Antibody) at dilution 1/50, on the right is treated with fusion protein. (Original magnification: ×200)
-
The image on the left is immunohistochemistry of paraffin-embedded Human cervical cancer tissue using CSB-PA552720(APTX Antibody) at dilution 1/50, on the right is treated with fusion protein. (Original magnification: ×200)
-
-
其他:
產(chǎn)品詳情
-
Uniprot No.:
-
基因名:APTX
-
別名:AOA 1 antibody; AOA antibody; AOA1 antibody; Aprataxin antibody; Aprataxin homolog antibody; Aptx antibody; APTX_HUMAN antibody; Ataxia 1 early onset with hypoalbuminemia antibody; Ataxia1 early onset with hypoalbuminemia antibody; AXA 1 antibody; AXA1 antibody; EAOH antibody; EOAHA antibody; FHA HIT antibody; FHA-HIT antibody; FLJ20157 antibody; Forkhead associated domain histidine triad like antibody; Forkhead associated domain histidine triad like protein antibody; Forkhead-associated domain histidine triad-like protein antibody; MGC1072 antibody
-
宿主:Rabbit
-
反應種屬:Human,Mouse,Rat
-
免疫原:Fusion protein of Human APTX
-
免疫原種屬:Homo sapiens (Human)
-
標記方式:Non-conjugated
-
抗體亞型:IgG
-
純化方式:Antigen affinity purification
-
濃度:It differs from different batches. Please contact us to confirm it.
-
保存緩沖液:-20°C, pH7.4 PBS, 0.05% NaN3, 40% Glycerol
-
產(chǎn)品提供形式:Liquid
-
應用范圍:ELISA,IHC
-
推薦稀釋比:
Application Recommended Dilution ELISA 1:1000-1:5000 IHC 1:50-1:200 -
Protocols:
-
儲存條件:Upon receipt, store at -20°C or -80°C. Avoid repeated freeze.
-
貨期:Basically, we can dispatch the products out in 1-3 working days after receiving your orders. Delivery time maybe differs from different purchasing way or location, please kindly consult your local distributors for specific delivery time.
-
用途:For Research Use Only. Not for use in diagnostic or therapeutic procedures.
相關產(chǎn)品
靶點詳情
-
功能:DNA-binding protein involved in single-strand DNA break repair, double-strand DNA break repair and base excision repair. Resolves abortive DNA ligation intermediates formed either at base excision sites, or when DNA ligases attempt to repair non-ligatable breaks induced by reactive oxygen species. Catalyzes the release of adenylate groups covalently linked to 5'-phosphate termini, resulting in the production of 5'-phosphate termini that can be efficiently rejoined. Also able to hydrolyze adenosine 5'-monophosphoramidate (AMP-NH(2)) and diadenosine tetraphosphate (AppppA), but with lower catalytic activity. Likewise, catalyzes the release of 3'-linked guanosine (DNAppG) and inosine (DNAppI) from DNA, but has higher specific activity with 5'-linked adenosine (AppDNA).
-
基因功能參考文獻:
- we demonstrated that miR-424 regulated radiosensitivity by directly targeting aprataxin. PMID: 27769049
- Whole-exome sequencing on a large consanguineous Iranian family with hereditary ataxia and oculomotor apraxia resulted in the identification of a homozygous novel stop-gain mutation in the APTX gene (c.739A>T; p.Lys247*) that segregates with the phenotype. PMID: 28652255
- Mutations in TDP1 and APTX have been linked to Spinocerebellar ataxia with axonal neuropathy (SCAN1) and Ataxia-ocular motor apraxia 1 (AOA1), respectively, while mutations in PNKP are considered to be responsible for Microcephaly with seizures (MCSZ) and Ataxia-ocular motor apraxia 4 (AOA4). PMID: 27470939
- Lack of aprataxin impairs mitochondrial functions via downregulation of the APE1/NRF1/NRF2 pathway. PMID: 25976310
- Herein, we survey APTX function and the emerging cell biological, structural and biochemical data that has established a molecular foundation for understanding the APTX mediated deadenylation reaction. [review] PMID: 25637650
- We describe an ataxia with oculomotor apraxia type 1 patient without a severe phenotype, who has a homozygous deletion of the complete coding region of APTX. PMID: 26285866
- TDP1 and APTX take part in the mitochondrial DNA repair and are apparently being transported from the cell nucleus. (Review) PMID: 24161509
- Structure-function studies of human APTX-RNA-DNA-AMP-Zn complexes define a mechanism for detecting and reversing adenylation at RNA-DNA junctions PMID: 24362567
- Data suggest that mutations affecting protein folding, the active site pocket and the pivot motif underlie aprataxin dysfunction in the neurodegenerative disorder ataxia with oculomotor apraxia 1 (AOA1). PMID: 21984210
- The clinical phenotype was homogeneous, irrespectively of the type and location of the APTX mutation, and it was mainly characterized by early-onset cerebellar signs, sensory neuropathy, cognitive decline, and oculomotor deficits. PMID: 21465257
- Aprataxin is required for the normal repair rate of DNA single-strand breaks induced by genotoxic agents. PMID: 21412945
- The patients with early onset ataxia with ocular motor apraxia and hypoalbuminaemia homozygous for the c.689_690insT mutation(APTX) show a more severe phenotype than those with a p.Pro206Leu or p.Val263Gly mutation. PMID: 21486904
- Aprataxin localizes to mitochondria and preserves mitochondrial function. PMID: 21502511
- Loss of HNT3 in rad27Delta cells, which are deficient in long-patch base excision repair (LP-BER), resulted in synergistic sensitivity to H(2)O(2) and methylmethane sulfonate. PMID: 20399152
- searched for aprataxin mutations in Greek patients with sporadic cerebellar ataxia where GAA expansion in frataxin gene has been excluded; no detectable point mutation or deletion was found in the aprataxin gene of all the patients PMID: 19953284
- High aprataxin levels are associated with low irinotecan response in colorectal cancer. PMID: 20371676
- Data demonstrate the presence of elevated levels of oxidative DNA damage in AOA1 cells coupled with reduced base excision and gap filling repair efficiencies indicative of a synergy between aprataxin, PARP-1, APE-1 and OGG1 in the DNA damage response. PMID: 19643912
- Data show that the RASGRP1/APTX gene expression ratio was higher in the responder while the AKAP13 expression was higher in the non-responders. PMID: 19960345
- The clinical and genetic features of three non-Portuguese and non-Japanese patients with aprataxin gene mutations are reported. PMID: 12629250
- A 14 year old girl presented with severe generalized dystonia, ataxia, ocular motor apraxia, and areflexia. and homozygous for an insertion mutation of aprataxin (APTX), 689 ins T. PMID: 14534929
- aprataxin influences the cellular response to genotoxic stress. PMID: 15044383
- This study screened a group of 165 early onset ataxia patients for APTX mutations and detected two non-related patients homozygous for the W293X nonsense mutation. PMID: 15164193
- Two novel mutations were identified, the complete deletion of the gene, which seems to not correlate with an increased severity of the disease, and a splice mutation on the acceptor splice site of exon 7 (875-1G>A (IVS7-1 G>A). PMID: 15365154
- Aprataxin is physically associated with both the DNA single-strand and double-strand break repair machinery, raising the possibility that AOA1 is a novel DNA damage response-defective disease. PMID: 15380105
- determined the domains of APTX and XRCC1 required for their interaction; findings suggest that APTX, together with XRCC1 and PARP-1, plays an essential role in single-strand DNA break repair PMID: 15555565
- A novel homozygous missense mutation (H201Q) was found in one Italian patient. PMID: 15596775
- Aprataxin was shown to be involved directly in the DNA single-strand-break repair machinery. PMID: 15719174
- the essential function of Aprataxin is reversal of nucleotidylylated protein modifications; all three domains contribute to formation of a stable enzyme, and the in vitro behavior of cloned APTX alleles can score disease-associated mutations PMID: 15790557
- Aprataxin has a role in the cellular response to DNA damage PMID: 16547001
- cross-dependence between aprataxin and nucleolin in the nucleolus PMID: 16777843
- 2 patients whose clinical features resembled those of multiple system atrophy of the cerebellar subtype (MSA-C) but without ocular motor apraxia and hypoalbuminemia. Each had a different nucleotide transition in the APTX gene. PMID: 17049295
- Aprataxin is critical for the processing of obstructive DNA termini. PMID: 17240329
- May have a general proofreading function in DNA repair, removing DNA adenylates as they arise during single-strand break repair, double-strand break repair, and in base excision repair. PMID: 17276982
- All of the disease-associated apprataxin mutants had extremely shorter half-lives than the WT. We further found that these mutants were targeted for rapid proteasome-mediated degradation PMID: 17485165
- Aprataxin repairs DNA single-strand breaks with a unique substrate specificity toward damaged 3'-ends including 3'-phosphoglycolate and 3'-phosphate ends, and that disease-associated mutant forms of aprataxin lack this activity. PMID: 17519253
- Expression studies by Western blotting on fibroblasts demonstrated that the homozygous Val230Gly mutation was associated with decreased levels of APTX indicating a loss-of-function mechanism. PMID: 17572444
- We report a patient with homozygous deletion of APTX, who presented with behavioural changes (social withdrawal), and subsequent rapid progression of neurological symptoms associated with severe cognitive decline. PMID: 18202221
- APTX is the first protein to adopt canonical histidine triad-type reaction chemistry for the repair of DNA PMID: 18836178
- that short-patch single-strand break repair (SSBR) in AOA1 cell extracts bypasses the point of aprataxin action at oxidative breaks and stalls at the final step of DNA ligation, resulting in the accumulation of adenylated DNA nicks PMID: 19103743
- Protein kinase C gamma, a causative for spinocerebellar ataxia, negatively regulates nuclear import of aprataxin. PMID: 19561170
顯示更多
收起更多
-
相關疾病:Ataxia-oculomotor apraxia syndrome (AOA)
-
亞細胞定位:Nucleus, nucleoplasm. Nucleus, nucleolus.; [Isoform 12]: Cytoplasm.
-
組織特異性:Widely expressed; detected in liver, kidney and lymph node (at protein level). Isoform 1 is highly expressed in the cerebral cortex and cerebellum, compared to isoform 2 (at protein level). Widely expressed; detected throughout the brain, in liver, kidney
-
數(shù)據(jù)庫鏈接:
Most popular with customers
-
YWHAB Recombinant Monoclonal Antibody
Applications: ELISA, WB, IHC, IF, FC
Species Reactivity: Human, Mouse, Rat
-
Phospho-YAP1 (S127) Recombinant Monoclonal Antibody
Applications: ELISA, WB, IHC
Species Reactivity: Human
-
-
-
-
-
-